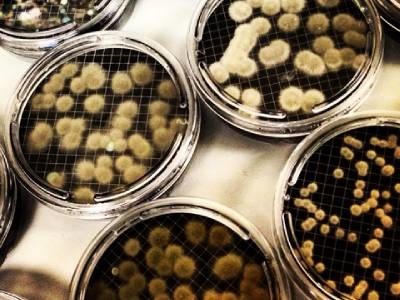
Membrane Filtration: Advantages and Modern Advancements

by Katherine Hood, Digital Marketing Manager, Pall Laboratory
The Membrane Filtration Method has come a long way in recent years, with improvements in membrane technology and new protocols to handle challenging samples. The Membrane Filtration Method is rapidly becoming the simplest and most comprehensive test for contamination in everything from drinking water to pharmaceuticals, and from food to environmental samples.
Read more on Labcompare.